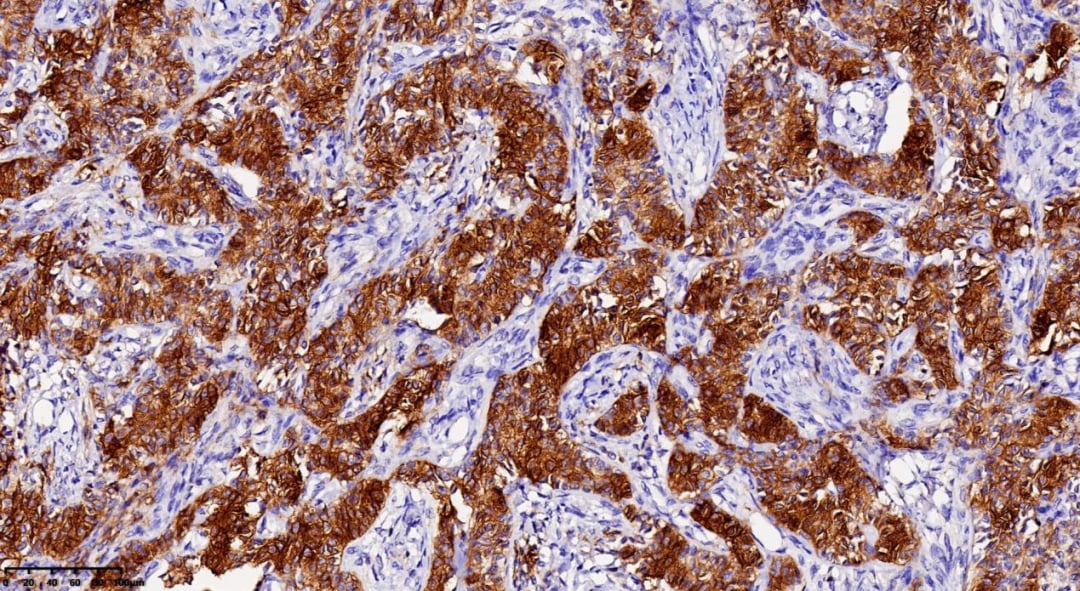
图片
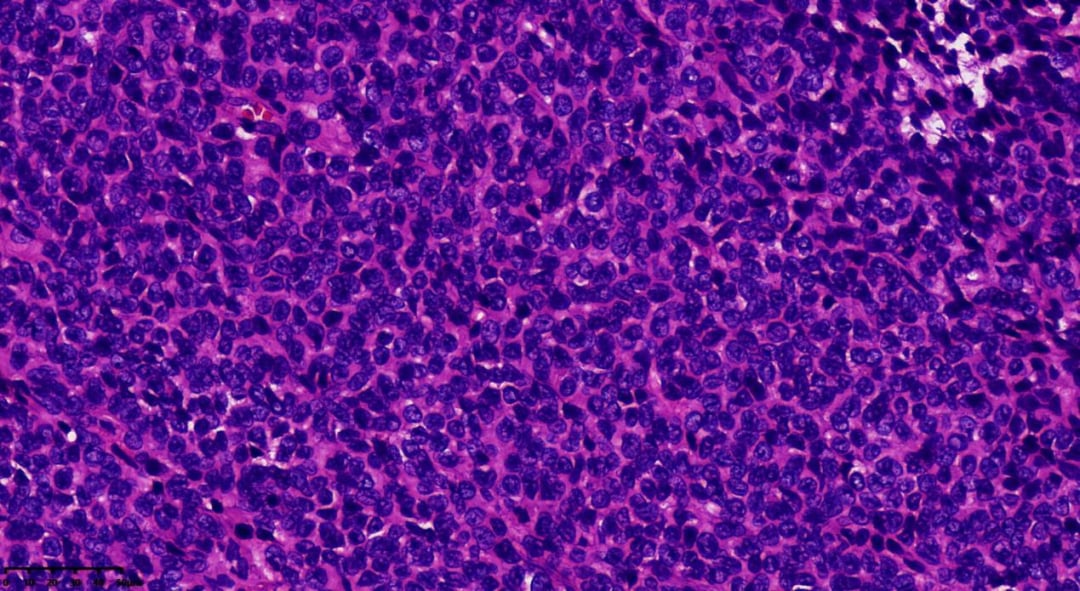
图片
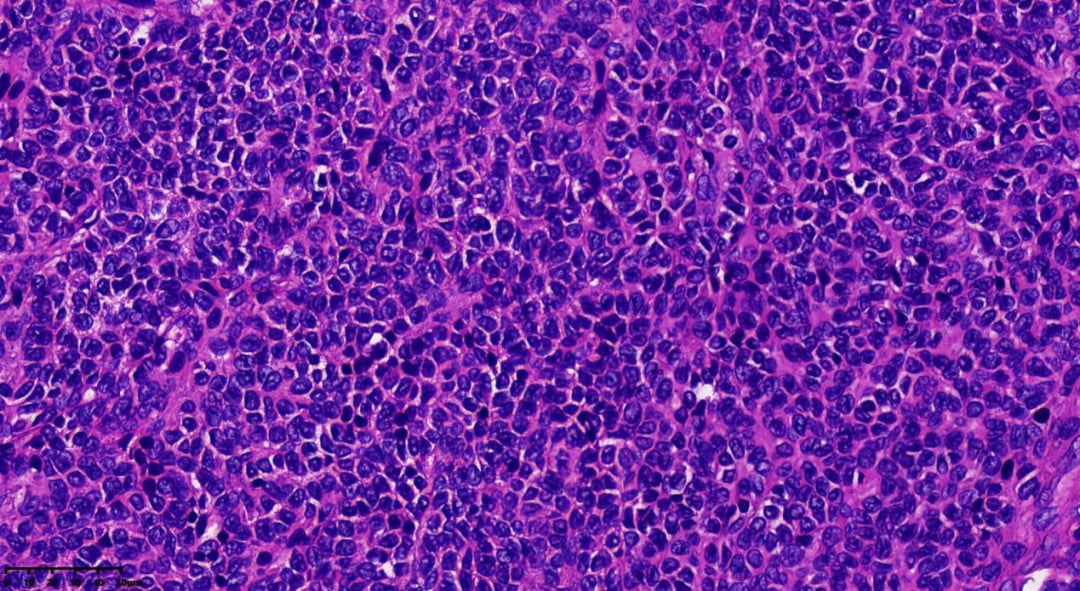
图片

引言
在复杂的肿瘤世界中,卵巢成年型粒层细胞瘤(Adult Granulosa Cell Tumors, AGCT)作为一种相对罕见的性索-间质肿瘤,对患者的诊断和治疗提出了独特的挑战。它不仅是卵巢癌的一种特殊类型,其临床表现、病理特征及分子机制都具有显著的独特性。本文将通过一个真实的病例,结合详细的医学知识,深入剖析AGCT的方方面面,旨在帮助患者、家属及医疗专业人士更好地理解这一疾病,并探讨在抗癌之路上如何获取前沿的靶向药和专业支持。
真实病例回顾:一位54岁女性的诊断之旅
我们来看一个典型的成年型粒层细胞瘤病例。患者为一名54岁女性,已绝经两年,因持续两个多月的不规则阴道流血就诊,出血量少于正常月经量。初步的超声检查揭示盆腔内存在一个尺寸约为125×106×105mm的混合性肿块,其性质尚待明确。
在后续的大体检查中,医生发现患者的卵巢大小显著增大,达到12×10×6cm,切面呈实性,颜色介于灰白与灰黄色之间,质地较软,并带有完整的包膜。这些宏观特征为后续的病理诊断提供了重要线索。
形态学特征:显微镜下的肿瘤世界
在显微镜下,肿瘤细胞呈现出多种独特的排列模式,为病理诊断提供了关键依据:

肿瘤呈巢状、岛屿状分布,细胞较小

肿瘤呈巢状、岛屿状分布,细胞较小

肿瘤呈梁状、条索状分布

肿瘤呈梁状、条索状分布

肿瘤弥漫性分布,肿瘤细胞胞质相对较少,呈单一表现

肿瘤弥漫性分布,肿瘤细胞胞质相对较少,呈单一表现

出现囊性变区域

可见间质分隔

瘤细胞一般胞质稀少,大小较一致,细胞界线不清,卵圆形或多边形,细胞核轮廓不规则,可见核沟或核呈咖啡豆状。核分裂象少见

瘤细胞一般胞质稀少,大小较一致,细胞界线不清,卵圆形或多边形,细胞核轮廓不规则,可见核沟或核呈咖啡豆状。核分裂象少见

可见Call-Exner小体
免疫组化结果:分子层面的证据
为了进一步明确诊断,进行了免疫组化染色。结果显示:

FOXL2

CD56

Inhibin α
Vimentin
最终,结合所有检查结果,该患者被确诊为:(右卵巢)成年型粒层细胞瘤(有包膜)。
深入了解成年型粒层细胞瘤(AGCT)
什么是成年型粒层细胞瘤?
成年型粒层细胞瘤(AGCT)是一种由不同生长模式的粒层细胞与不同比例的成纤维细胞或卵泡膜细胞混合组成的肿瘤。其ICD-O编码为8620/3。
临床表现与流行病学
- AGCT是性索-间质肿瘤中最常见的类型,约占所有卵巢恶性肿瘤的2%,在所有粒层细胞瘤中占比高达95%。
- 该肿瘤可发生于任何年龄段,但主要集中在中年或绝经后女性,约5%的病例发生在青春期前。
- 临床上,患者常表现为附件区肿物和雌激素分泌增高的相关症状。约10%的患者可能出现腹水,另有10%的患者症状隐匿。
- 对于青春期前患者,可能出现假性早熟;育龄妇女则常表现为月经不规律、经期延长、乳房胀痛等,部分患者还可能伴发子宫内膜增生症,甚至少数可发展为子宫内膜癌。极少数单房囊性肿瘤患者甚至可能出现男性化症状。
病理学特征:大体与组织学
- 大体病理学:多数AGCT为单侧性,表面光滑或呈结节状,通常包膜完整。肿瘤大小差异显著,平均直径约12cm,切面呈囊实性或实性,颜色多为灰黄色,质地柔软。多数肿瘤可见出血和灶性坏死,囊性区域可呈多房或单房,内含浆液或陈旧性出血。
- 组织病理学:瘤组织排列模式多样,同一肿瘤内可能出现多种结构,包括弥漫性、结节状、小梁状、条索样、岛屿状、滤泡状、波浪状、脑回样及肉瘤样。少数病例可见囊性变区域,甚至形成假乳头。瘤细胞通常胞质稀少、淡染,大小相对一致,界线不清,呈卵圆形或多边形,细胞核轮廓不规则,可见核沟或呈咖啡豆状。核分裂象通常较少见,75%的病例中每10个高倍视野(HPF)少于3个。
- Call-Exner小体是AGCT的典型特征,表现为瘤细胞围绕中心腔无定向排列,中心腔内含有核碎屑的嗜酸性分泌物或基底膜样粉染物。
- 部分瘤细胞可能发生黄素化,细胞变大变圆,胞质丰富淡染或嗜酸性,富含脂质,类似黄体细胞,此时核沟不明显,核仁更清晰。
免疫组化与分子病理学:FOXL2基因的关键作用
- 免疫组化:AGCT通常表达性索分化标记物,如inhibin、calretinin、CD99、类固醇生成因子(SF-1)和WT1。其中,α-inhibin的特异性优于Calretinin。
- FOXL2基因:值得注意的是,高达97%的AGCT病例表达FOXL2。更重要的是,超过90%的AGCT存在FOXL2基因点突变,这一突变被认为是AGCT发生发展的重要驱动因素。
- 其他常见阳性标记物包括CD56、vimentin、S100、SMA、CD10(通常弱阳性)。间质成分可表达desmin。CK灶状阳性,而CK7、CK20和EMA通常为阴性。
- 分子病理学:除了FOXL2基因突变,粒层细胞瘤多数还表现出12号和14号染色体三倍体,以及16号染色体单倍体。
鉴别诊断:避免误诊的关键
AGCT的诊断需要与多种肿瘤进行鉴别,以确保治疗的准确性:
- 成年型与幼年型粒层细胞瘤:两者在临床特征和组织学上存在明显差异。
- 子宫内膜样癌:其腺管结构有时与AGCT的Call-Exner小体相似,但前者常伴有鳞化,细胞核无核沟,且部分病例伴发子宫内膜异位症。免疫表型上,子宫内膜样癌EMA、CK7阳性,而α-inhibin、Calretinin等阴性。
- 类癌:卵巢类癌也可呈岛状或梁索状生长,但类癌细胞核呈一致性圆形,无核沟,免疫组化示CgA、syn阳性,而α-inhibin、WT1阴性。
- 卵泡膜细胞瘤:网状纤维染色是鉴别卵泡膜细胞瘤与弥漫型AGCT的有效方法。弥漫排列的粒层细胞瘤网状纤维分布在细胞巢周围,而卵泡膜细胞瘤的网状纤维分布在每一个肿瘤细胞周围。
生物学行为与预后
成年型粒层细胞瘤通常被认为是一种低度恶性潜能的肿瘤,其主要特点是可能出现远期盆腹腔复发。预后情况与肿瘤分期密切相关:I期肿瘤的10年生存率可达86%~96%,而更高分期的肿瘤生存率则显著降低至26%~49%。对于IC期患者,25年生存率会进一步降低至60%~86%。
抗癌之路:获取前沿靶向药与专业支持
面对卵巢癌等各类恶性肿瘤,精准的诊断是治疗的第一步,而获取合适的抗癌药,尤其是靶向药,则是决定治疗效果的关键。许多患者在寻求最佳治疗方案时,会面临国内药物选择有限、新药上市滞后或药品价格高昂等挑战,从而将目光投向海外市场,寻求海外购药或药品代购服务。
MedFind致力于为全球癌症患者提供一站式解决方案。我们深知患者对前沿治疗的渴望,因此提供便捷可靠的海外靶向药代购服务,帮助患者获取国内难以买到的抗癌药和仿制药。无论您正在寻找最新的靶向药,还是希望了解仿制药哪里购买,我们都能提供专业的支持。
此外,MedFind还提供AI问诊服务,通过智能算法为患者提供个性化的初步诊疗建议和药物信息,帮助您更好地理解病情和治疗选择。同时,我们的抗癌资讯平台汇集了丰富的药物信息、诊疗指南和前沿研究,助您在抗癌路上掌握更多知识,做出明智决策。
结语
成年型粒层细胞瘤的诊断和管理需要多学科协作,而对疾病的深入理解是患者和医生共同应对挑战的基础。通过本文的详细解析,我们希望能够为患者提供一份全面的卵巢癌知识指南。在抗癌的征程中,获取及时、准确的医疗信息和前沿药物至关重要。MedFind将持续为患者提供可靠的药品代购和专业咨询服务,助力每一位患者勇敢前行,拥抱希望。
